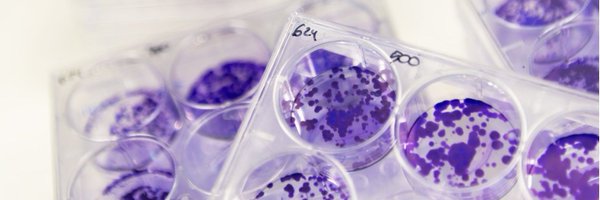

Vall d’Hebron Institute of Oncology (VHIO)
@VHIO
Followers
11K
Following
16K
Media
7K
Statuses
15K
Leading translational research to accelerate & advance personalized and targeted therapies against cancer. @iCERCA centre
C/ Natzaret, 115-117
Joined January 2019
Congreso @ASH_hematology #ASH25: una CAR-T se postula para 👉 leucemia linfoblástica aguda de células B. Pere Barba, del @vallhebron @VHIO, presenta los resultados del ensayo fase 1 que evalúa el #RapcabtageneAutoleucel, de @Novartis. ✍️@carmenfefe.
diariomedico.com
El científico español Pere Barba presenta los resultados del ensayo fase 1 que evalúa el rapcabtagene autoleucel, de Novartis.
0
1
2
🔴 Pere Barba acaba de presentar a #ASH25 una CAR-T de nova generació amb resultats prometedors en un assaig de fase 1 en #LLA-B refractària, fabricada en només 48 h gràcies a la plataforma T-Charge™. 🔗 https://t.co/aDemkJalHe
#CAIMI #AECCVHIO
0
4
11
Analogue 3D - Funtastic - Limited Editions. Available in highly limited quantities. Perfectly color matched to the originals N64 models. $299.99 On Sale: Dec 10, 8am PST. Shipping: Dec 10 with Guaranteed delivery before Christmas.
245
296
4K
🔴 Pere Barba acaba de presentar en #ASH25 una CAR-T de última generación con resultados prometedores en un ensayo de fase 1 en #LLA-B refractaria, fabricada en solo 48 h gracias a la plataforma T-Charge™. 🔗 https://t.co/34h9lQkiE0
#CAIMI #AECCVHIO
0
0
1
🔴 At #ASH25, Pere Barba shares phase 1 results of a next-gen CD19 CAR-T for refractory B-cell acute lymphoblastic leukaemia, showing manageable safety and antitumour activity. Manufactured in just 48h using the T-Charge™ platform 🔗 https://t.co/ALv6NCwVU2
#CAIMI #AECCVHIO
1
2
8
🔬 Una #biòpsialíquida pot millorar el diagnòstic i el seguiment del #càncerdebufeta. El Dr. Morales Barrera, investigador del VHIO i oncòleg a @vallhebron ha participat en aquest estudi que mostra quins pacients necessiten immunoteràpia després de la cirurgia. @som3cat:
linke.to
0
2
5
Web designers like @reijowrites bring powerful interactions to the web with one platform: Framer
0
4
52
🎙 Recuperamos un capítulo de #Cancer360 ‼️ 🔹 La próxima revolución de las terapias avanzadas en cáncer 💬 @alena_grosvidal, @smartinlluesma, Pere Barba y @joaquinarribas, conducido por @adammartinsk 🎧 👉 https://t.co/IlYNgMExI3
#SOMMVHIO #CAIMI #AECCVHIO @iCERCA
0
0
0
🎓✨ Esta semana hemos sabido que cerca de 65 personas se han sumado a la 20ª edición del Curso de #EnsayosClínicos en #Oncología y #Hematología del VHIO. 🚀 ¡Gracias por participar en esta edición tan especial e impulsar la investigación clínica del futuro❗ #ClinicalTrials
0
0
5
🩸 Los y las #ResisHematoVH ya están en el #ASH25 🙌 Jonay (R3), Anna Martín (R3), Marina (R4) y Sergi (R4) participan estos días en el congreso anual de la @ASH_hematology para seguir formándose, compartir conocimiento y acercar los últimos avances en #Hematología. #ASH25
0
3
4
Esta semana hemos sabido que un estudio liderado por @LauraSoucek y Fabio Giuntini del #VHIO muestra que combinar el inhibidor de MYC Omomyc -desarrollado por @peptomyc- con terapias dirigidas a la reparación del ADN potencia la actividad antitumoral en modelos preclínicos de
1
0
8
Need a job? Join ICE today. ICE offers competitive salaries & benefits like health insurance and retirement plans.
12K
21K
120K
¡Así celebramos la primera Jornada de Donantes del VHIO❗ Un espacio de encuentro, reconocimiento y gratitud hacia todas las personas e iniciativas que hacen posible la investigación del cáncer en nuestra institución. 👏 ¡Gracias por acompañarnos y por vuestra solidaridad!
0
0
0
🔬 En #VHIO recibimos a investigadores e investigadoras del @ISGLOBALorg en un taller sobre prevención del cáncer, diagnóstico precoz y nuevas vías de colaboración. 🤝 Con @TaberneroJosep, Denise Naniche y especialistas de ambos centros, exploramos sinergias y una hoja de ruta
0
0
4
El profesor Saar Gill (University of Pennsylvania) participó en el #VHIOBBVASymposium, donde compartió su visión para democratizar la terapia CAR-T gracias a estrategias que simplifican su fabricación y amplían el acceso a más pacientes, incluso en entornos con menos recursos.
🗣️ Saar Gill (profesor de la Universidad de Pensilvania): "Nuestro objetivo es 'democratizar' las #CART". ➡️Este médico y científico busca simplificar la fabricación de la #TerapiaAvanzada para ampliar su acceso.
0
0
0
💬 "Es interesante dar visibilidad a los tumores raros para que los pacientes podamos conseguir mejores tratamientos" 🎥 En la última #VHIOTalks25 profesionales y pacientes compartieron dudas y experiencias sobre tumores neuroendocrinos. #SOMMVHIO @SOMM_alliance @FCLP_Fundacio
0
1
7
Lenders can more easily work with state and local agencies to find grants and programs that may help borrowers afford a home thanks to our streamlined resources. Learn how.
0
4
36
🔬 En VHIO trabajamos para transformar los últimos hallazgos del laboratorio en #EnsayosClínicos que den lugar a mejores tratamientos para los y las pacientes. Ayúdanos a seguir avanzando, haz tu donación aquí 👉 https://t.co/kcMZnaj7Yu
#Investigacióndelcáncer
0
0
1
🧪Our HER3-DXd biomarker study in BC PDXs is out in @Nature_NPJ! Key findings🔎 Long-term response associated to: 🧫Basal-like subtype 💊low chemo exposure 🎯high TOP1i sensitivity 🔗 https://t.co/ao8My1cpCN Led by @vserra_elizalde @MOliveira_MD (@VHIO) & @prat_aleix (@idibaps)
nature.com
npj Precision Oncology - Determinants of long-term response to patritumab deruxtecan in breast cancer patient-derived xenografts
0
2
4
Ahir hem celebrat la primera Jornada de Donants del VHIO❗ Un espai de trobada, reconeixement i gratitud cap a totes les persones i iniciatives que fan possible la recerca en càncer a la nostra institució. 👏 Gràcies per acompanyar-nos i per la vostra solidaritat!
0
1
2
⚠️ Últims dies per inscriure’t al #VHIO4STEM26! 🌟 🔬 El programa del #VHIO per fomentar vocacions científiques entre nois i noies de 4t d’ESO. 👩🔬 4 dies d’immersió als nostres laboratoris amb mentoria personalitzada. 📅 Inscripcions 👉 https://t.co/7dnPzZyt0J
#SOMMVHIO
0
0
0
.@KimStrassel: “I shiver to think about how close we came to full-on censorship under this last administration.”
1K
12K
45K
Honored to deliver a keynote today at @vallhebron’s 19th Scientific Day & 29th Annual Conference on collaborative, challenge-driven research with transformative health impact. Talk: “Developing a clinically viable MYC inhibitor: to boldly go where no one has gone before.” @VHIO
0
1
10
Un estudi coliderat per la #investigadoraICREA @LauraSoucek (@LSoucekLab) mostra que Omomyc —el fàrmac creat per la spin-off d'ICREA i VHIO @peptomyc— pot ser una estratègia terapèutica per combatre el càncer de mama triple negatiu. 🔗Consulta la notícia:
cronicaglobal.elespanol.com
La inhibició de MYC amb el fàrmac Omomyc es revela com una prometedora diana terapèutica, especialment en combinació amb inhibidors de PARP Relacionades: A la zona zero de la pesta porcina de...
🧬 Publicat a @CellReports: combinar l’inhibidor de MYC Omomyc amb teràpies dirigides a la reparació de l’ADN potencia l’activitat antitumoral en models preclínics de càncer de mama triple negatiu. 🗞️ L’estudi està liderat per @LauraSoucek i Fabio Giuntini, del grup de
0
3
6
@LauraSoucek @VHIO Vols descobrir tot el que ha passat a la #19JornadaCientíficaVH? Hem gaudit de conferències que ens han permès conèixer alguns dels projectes més destacats de @vallhebron. Llegeix la notícia! 👇 https://t.co/nrRcFwqWy1
0
1
0